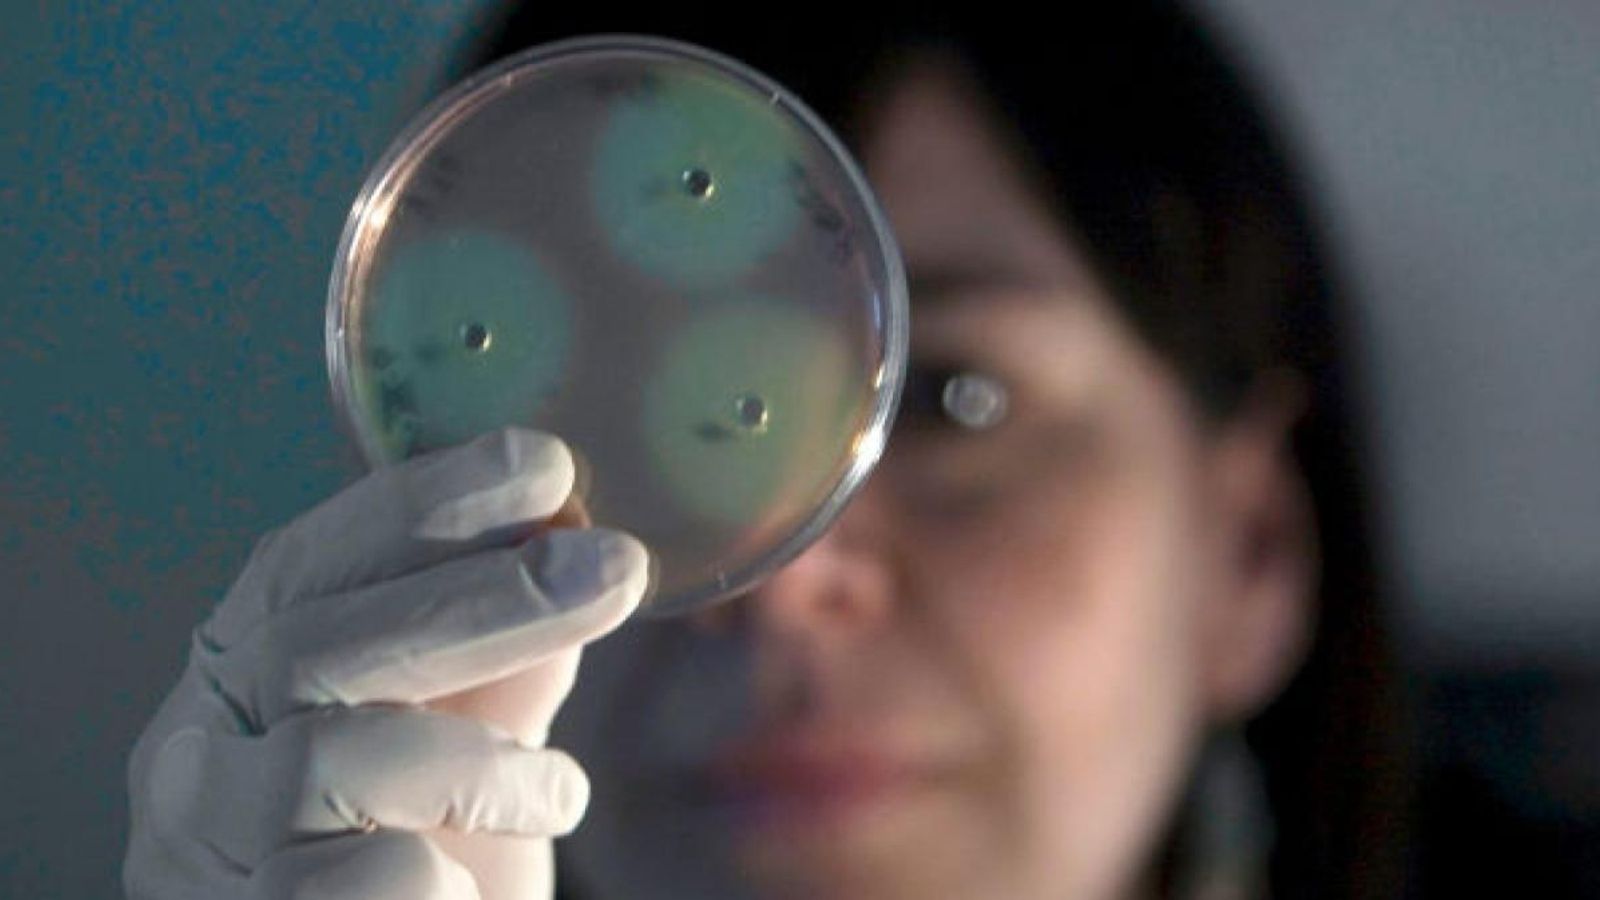

Com alimentar-nos saludablement quan anem a la platja?
Es recomana ingerir fruita, verdura, fruits secs i proteïna, però sobretot mantindre's ben hidratats amb aigua
Anar a passar el dia a la natura o la platja implica tota una preparació logística, i un repte a l'hora de triar i preparar el menjar. Entre les preferències dels usuaris podem trobar fruita madura, rosquilletes, sandvitxos, papes, sucs o galetes.
Però que ens recomanen les veus expertes de la nutrició? Per damunt de tot es prioritza mantindre's ben hidratats per a resistir la calor i les altes temperatures.
Així mateix, amb els aliments com la fruita o les verdures, que aporten gran quantitat d’aigua, anem pel bon camí. Alhora, podem prendre també fruits secs, que contenen greixos saludables i aporten energia, cosa que ens farà no decaure.
“Si vols afegir més proteïnes a l’hora de la picadeta, el peix en conserva és perfecte”, explica la nutricionista Elisa Escorihuela.
Els batuts de fruita també són una opció saludable, refrescant i abellidora, que a més ens mantindrà hidratats. No obstant això, la beguda principal sempre haurà de ser l’aigua.
“Sobretot hem d’evitar begudes amb alcohol, perquè deshidraten. Si estem a la platja i exposats al sol i fa una temperatura elevada, podríem patir una deshidratació”, afig Escorihuela. I és que gaudir de la platja i menjar bé no han d'estar barallats.